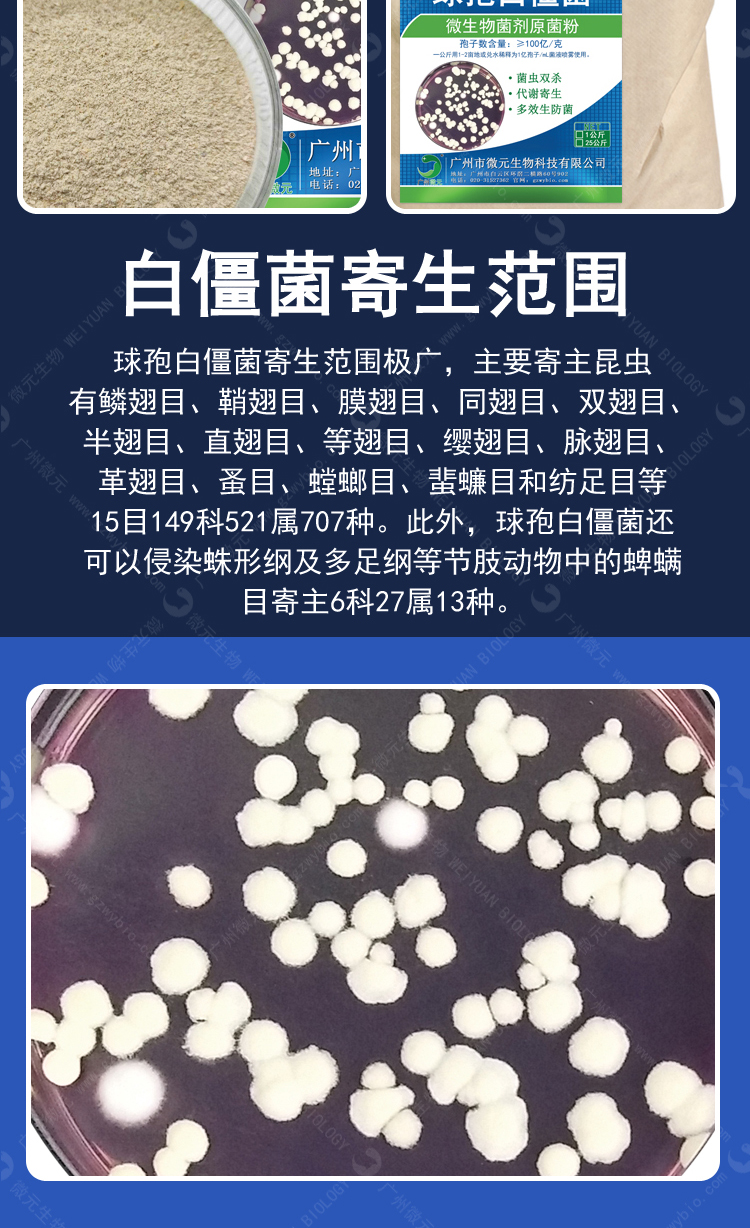

微元-球孢白僵菌
【菌種成分】球孢白僵菌 【菌種狀態】原菌粉
【菌溶解性】可溶 【菌種含量】有效活菌數≥100億/克
【產品概述】
微元球孢白僵菌(Beauveria bassiana)是世界上研究和應用較多的昆蟲病原真菌之一,其分生孢子的表面具有粗糙的皺折,它是一種β-胡蘿卜醇的聚合物,能增強分生孢子對不良環境的抵抗力,對許多農林害蟲是有效的侵染體,可侵染包括 15 個 目、149 個科的 700 多種昆蟲及蜱螨目的 6 科 10 余種螨和蜱。自 20 世紀 70 年代以來我國應用此菌防治農林害蟲的規模一直居世界前列,尤其是在利用球孢白僵菌防治亞洲玉米螟和馬尾松毛蟲的應用上。1991年Bing和Lewis首次發現了球孢白僵菌的植物內生性,為對利用白僵菌植物內生性提高作 物抗蟲能力提供了新思路。
【適用范圍】
球孢白僵菌防治害蟲范圍廣,應用于森林害蟲,蔬菜害蟲,旱地農作物害蟲等。白僵菌寄生在害蟲體內,并蠶食蟲體內養分,在其體表產生孢子并釋放出來,讓害蟲相互傳染。主要寄主昆蟲有鱗翅目、鞘翅目、膜翅目、同翅目、雙翅目、半翅目、直翅目、等翅目、纓翅目、脈翅目、革翅目、蚤目、螳螂目、蜚蠊目和紡足目等15目149科521屬707種。此外,球孢白僵菌還可以侵染蛛形綱及多足綱等節肢動物中的蜱螨目寄主6科27屬13種。生產上多用于防治松毛蟲、松葉蜂、松尺蠖、松梢螟、松小蠹、天牛、女貞尺蛾、玉米螟、甘薯象甲、麥蝽象、棉紅蜘蛛、大豆食心蟲、菜青蟲、馬鈴薯象甲、桃小食心蟲、板栗象甲、地老虎、金龜甲、螻蛄、叩頭蟲、葉甲、蝽、蝗、葉蜂、葉蟬、蚊、蟻等害蟲。在我國主要用來防治甘薯象甲、大豆食心蟲、地老虎、玉米螟、棉鈴蟲、黏蟲、稻黑尾葉蟬、稻飛虱、三化螟、稻苞蟲類、茶樹小黃卷葉蛾、茶毛蟲、三葉草夜蛾、甜菜象甲、油菜象甲、金龜甲、葉甲、油菜尺蠖、馬鈴薯二十八星瓢蟲、菜青蟲、甘藍夜蛾、蘋果蠹蛾、桃小、天牛、松毛蟲等害蟲。
【作用方式】
球孢白僵菌菌落為白色粉狀物,菌體遇到較高的溫度自然死亡而失效。其有效物質是白僵菌的活孢子,孢子接觸害蟲或者害蟲直接吃進身體后,在適宜的溫度條件下萌發,生長菌絲入侵蟲體內,約經4-5天后死亡。死亡的蟲體白色僵硬,體表長滿菌絲及白色粉狀孢子,孢子可借風、昆蟲等繼續擴散,浸染其他害蟲。
【產品功效】
1、分解、降解作用:哈茨木霉是產纖維素酶活性比較高的菌株之一,所產生的纖維素酶對作物秸稈有降解作用,并能強力分解粗纖維、木質素等大分子有機物,使其轉化為利于植物吸收利用的小分子物質,效果非常好。
2、防治多種作物病害:木霉菌素通過產生抗生素、營養競爭、微寄生、細胞壁分解酵素、以及誘導植物產生抗性等機制,對多種植物病原菌既有拮抗作用,具有保護和治liao雙重功效,可以有效防治土傳性真菌病害,也可用于防止灰霉病。
【注意事項】
(1)本產品不能與殺菌劑同時灌根施用;
(2)施用本產品需要保持土壤濕潤,以免土壤干燥而影響微生物的作用;
(3)本產品應存放在陰涼干燥處,避免陽光直射,開封后未用完的產品應及時扎口密封儲存;
(4)開封后儲存過程中如有異味,屬于部分微生物菌被激活發酵所致,不影響效果。
注:本司僅對本產品質量負責,因其它因素造成的不當結果,概不負責。
【包裝容量】25kg/袋
【保存期限】12個月
【保存方法】請密封放置干燥陰涼避光處
【生產日期】見封口或打碼處


球孢白僵菌防治害蟲范圍廣,應用于森林害蟲,蔬菜害蟲,旱地農作物害蟲等。白僵菌寄生在害蟲體內,并蠶食蟲體內養分,在其體表產生孢子并釋放出來,讓害蟲相互傳染。主要寄主昆蟲有鱗翅目、鞘翅目、膜翅目、同翅目、雙翅目、半翅目、直翅目、等翅目、纓翅目、脈翅目、革翅目、蚤目、螳螂目、蜚蠊目和紡足目等15目149科521屬707種。此外,球孢白僵菌還可以侵染蛛形綱及多足綱等節肢動物中的蜱螨目寄主6科27屬13種。生產上多用于防治松毛蟲、松葉蜂、松尺蠖、松梢螟、松小蠹、天牛、女貞尺蛾、玉米螟、甘薯象甲、麥蝽象、棉紅蜘蛛、大豆食心蟲、菜青蟲、馬鈴薯象甲、桃小食心蟲、板栗象甲、地老虎、金龜甲、螻蛄、叩頭蟲、葉甲、蝽、蝗、葉蜂、葉蟬、蚊、蟻等害蟲。在我國主要用來防治甘薯象甲、大豆食心蟲、地老虎、玉米螟、棉鈴蟲、黏蟲、稻黑尾葉蟬、稻飛虱、三化螟、稻苞蟲類、茶樹小黃卷葉蛾、茶毛蟲、三葉草夜蛾、甜菜象甲、油菜象甲、金龜甲、葉甲、油菜尺蠖、馬鈴薯二十八星瓢蟲、菜青蟲、甘藍夜蛾、蘋果蠹蛾、桃小、天牛、松毛蟲等害蟲。
1、分解、降解作用:哈茨木霉是產纖維素酶活性比較高的菌株之一,所產生的纖維素酶對作物秸稈有降解作用,并能強力分解粗纖維、木質素等大分子有機物,使其轉化為利于植物吸收利用的小分子物質,效果非常好。
2、防治多種作物病害:木霉菌素通過產生抗生素、營養競爭、微寄生、細胞壁分解酵素、以及誘導植物產生抗性等機制,對多種植物病原菌既有拮抗作用,具有保護和治liao雙重功效,可以有效防治土傳性真菌病害,也可用于防止灰霉病。

(1)本產品不能與殺菌劑同時灌根施用;
(2)施用本產品需要保持土壤濕潤,以免土壤干燥而影響微生物的作用;
(3)本產品應存放在陰涼干燥處,避免陽光直射,開封后未用完的產品應及時扎口密封儲存;
(4)開封后儲存過程中如有異味,屬于部分微生物菌被激活發酵所致,不影響效果。